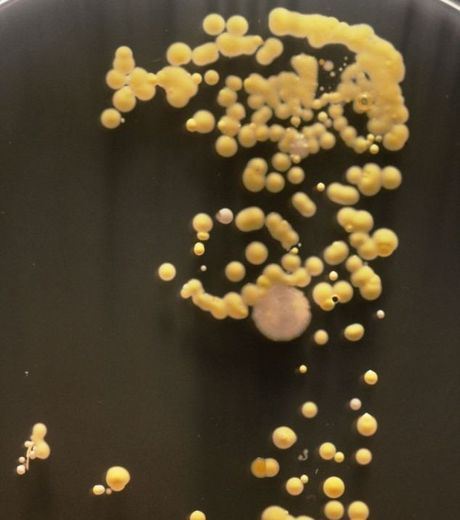

Tag: smart phones
-
The Dangerous Bacteria On Your Smartphone (gallery)
In England, a study has been conducted that confirms our smartphone is a medium of transmissions of bacteria. Students were able to observe many bacteria, harmless or not, on the smartphones screen. Whenever, someone uses a smartphone whether it is for SMS or to make a call, it leaves a microbiological imprint on the phone.…
-

LG To Launch Its Own Next Generation Smart Phone Watch
Apple, Google and Samsung are rumored to be in competition to make the next generation of smart watches. However, there is another company, South Koran giant LG electronics that also wants to grab this market. According to Korean press, in order to remain ahead of its competitors, LG is also building its own version of…